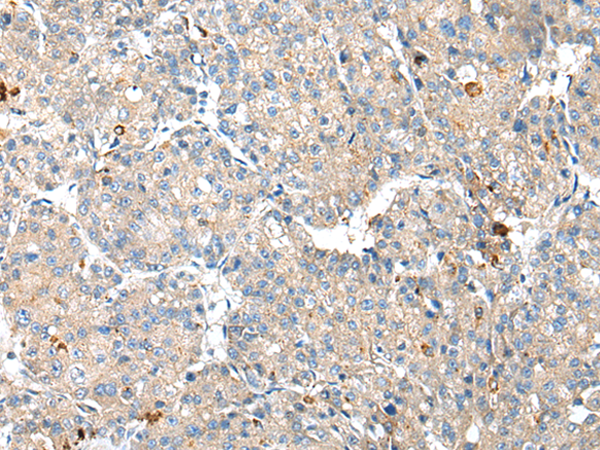

中文名稱: 兔抗RSPH1多克隆抗體
英文名稱: Anti-RSPH1 rabbit polyclonal antibody
抗 原: RSPH1
別 名: CT79; TSA2; RSP44; TSGA2; RSPH10A
宿 主: Rabbit
相關(guān)類別: 一抗
反應(yīng)種屬: Human
標(biāo) 記 物: Unconjugate
克隆類型: rabbit polyclonal
技術(shù)規(guī)格
|
Background: |
This gene encodes a male meiotic metaphase chromosome-associated acidic protein. This gene is expressed in tissues with motile cilia or flagella, including the trachea, lungs, airway brushings, and testes. Mutations in this gene result in primary ciliary dyskinesia-24. Alternatively spliced transcript variants encoding different isoforms have been found for this gene. |
|
Applications: |
ELISA, IHC |
|
Name of antibody: |
RSPH1 |
|
Immunogen: |
Fusion protein of human RSPH1 |
|
Full name: |
radial spoke head 1 homolog (Chlamydomonas) |
|
Synonyms: |
CT79; TSA2; RSP44; TSGA2; RSPH10A |
|
SwissProt: |
Q8WYR4 |
|
ELISA Recommended dilution: |
5000-10000 |
|
IHC positive control: |
Human liver cancer |
|
IHC Recommend dilution: |
25-100 |
購(gòu)物車
幫助
021-54845833/15800441009
